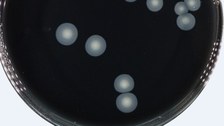
construction 3D-printer.

Seniorprofessur Bioverfahrenstechnik

© Haas

© Mulansky - Im Gegensatz zum Flügel der Zikade Megapomponia intermedia sind bei Cryptotympana mandarina im Rasterelektronenmikroskop nadelförmige Strukturen zu beobachten, die auch die Tracheen des Flügels bedecken

© Steudler

© Haas

© Lenk

© Stange - Ablaufschema bei der Biomagnetischen Separation.

© Schott

© Werner

© Schmidt

© Grothkopp - Zikade Megapomponia intermedia

© Mulansky - Bei der Untersuchung des Flügels der Zikade Megapomponia intermedia im Rasterelektronenmikroskop zeigen sich geordnete, kegelförmige Strukturen im Nanometerbereich. Sie bedecken den gesamten Flügel.

© Mulansky - Mikrostrukturiertes poröses Aluminiumoxid

© Mulansky - Durchflusskammer unter dem Fluoreszenzmikroskop

© Mulansky - 3D Aufnahme eines Biofilms und entsprechende iDynoMiCs-Simulationen

© Kühne - Probenplatte mit Biofilm nach drei Monaten im Europahafen Bremen.

© Kühne - Mit Antibiofouling-Lack beschichtete Proben nach einmonatigem Bewuchs im Müggelsee bei Berlin.

© Kühne - Bewachsene Proben im Rotationsgestell zum Abscheren der Biofilme im Wasserbad.

© Kühne - Biofilme auf Schiffslacken mit Antibiofouling-Eigenschaften.

© Stange - Magnetmixer mit speziell entwickelten Elektromagneten.

© Stange - Magnetfeldsimulation der Polschuhgeometrie der Elektromagneten.

© Sierra Sensors - Probenahme SPR-2.

© Zschätzsch - SPR Sensorgramm: Immobilisierung eines Liganden mittels Aminkopplung.

© Schott

© Schott

© Schott

© Lassig

© Schmidt

© Schmidt

© Haas

© Haas

© Steudler

© Steudler

© Steudler

© Werner

© Syngelaki

© Oberthuer

© Lauterbach

© Lenk

© Kamel

© Lauterbach

© Lauterbach

© Lenk

© Oberthuer

© Syngelaki

© Oberthuer

© Syngelaki

© Oberthuer

© Syngelaki
Die Bioverfahrenstechnik versteht sich als Brücke zwischen molekularbiologischer und mikrobiologischer Grundlagenforschung und der Realisierung biotechnischer Stoffumwandlungen im industriellen Maßstab. Die Nutzung von Naturstoffen (Weiße Biotechnologie) steht im Zentrum des Interesses. Mit Methoden zum schnellen Biomonitoring (Flow Cytometry, Magnetseparation in Kombination mit bildgebenden Verfahren, Biosensoren) werden zeitnah Informationen aus Zellfabriken gewonnen, auf deren Grundlage Stoffwechsel- und Prozessmodelle zur Beschreibung und Vorhersage biotechnischer Prozesse und damit zur Maßstabsübertragung genutzt werden können.
 © Christian Hüller
© Christian Hüller
Seniorprofessor für Bioverfahrenstechnik
NameProf. Dr. rer. nat. habil. Thomas Bley
Eine verschlüsselte E-Mail über das SecureMail-Portal versenden (nur für TUD-externe Personen).
Akademische Ausbildung
- Mathematikstudium an der Technischen Universität Dresden (bis 1975)
- Promotion über "Strukturierte Wachstumsmodelle - Vergleichende Untersuchungen und Anwendung auf Probleme der technischen Mikrobiologie" (1981)
- Habilitation zum Thema "Zustandsstrukturierte Modelle in der Biotechnologie - Anwendung von Delay-Differentialgleichungen zur Beschreibung der Dynamik mikrobieller Populationen" (1990)
Berufliche Stationen
- Wissenschaftlicher Mitarbeiter am Institut für Biotechnologie (IBT) der Akademie der Wissenschaften der DDR in Leipzig (1975 - 1990)
- Leiter der Abteilung Biosignale am IBT (1990 - 1991)
- Leiter des Projektes Biosignale im Wissenschaftler-Integrationsprogramm (1992 - 1993)
- Leiter der Abteilung Biotechnologie an der Fakultät für Biowissenschaften, Pharmazie und Psychologie der Universität Leipzig (1994 - 1996)
- Professor für Bioverfahrenstechnik an der Technischen Universität in Dresden (seit 1996)
- Seniorprofessor für Bioverfahrenstechnik an der Technischen Universität in Dresden (seit 2017)
Mitgliedschaften
- Ordentliches Mitglied der Sächsischen Akademie der Wissenschaften, Klasse Technikwissenschaften
- Ordentliches Mitglied der deutschen Akademie der Technikwissenschaften - acatech
- Mitglied des DFG-Fachkollegiums "Verfahrenstechnik, Technische Chemie"
- Vorsitzender der Beirates der GVC-DECHEMA Fachgruppe Bioprozesstechnik
- Mitglied des Vorstandes der DECHEMA-Fachgemeinschaft Biotechnologie
- Editor-in-Chief des Wiley-VCH Journals "Engineering in Life Sciences"
Forschungsschwerpunkte
- Biomonitoring und Biosignale (Flow Cytometry)
- Modellierung und Steuerung von Bioprozessen
- Biokatalyse in heterogenen Systemen
- Weiße Biotechnologie
- Pflanzenzellen in Bioreaktoren
Krujatz F, Härtel P, Helbig K, Haufe N, Thierfelder S, Bley T, Weber J (2015) Hydrogen production by Rhodobacter sphaeroides DSM 158 under intense irradiatio. Bioresource Technology 175, 82–90
Löser C, Urit T, Keil P, Bley T (2015) Studies on the mechanism of synthesis of ethyl acetate in Kluyveromyces marxianus DSM 5422. Applied Microbiology and Biotechnology 99, 1131-1144
Kümmeritz S, Haas C, Pavlov A, Geib D, Ulber R, Bley Th, Steingroewer J (2014) Determination of triterpenic acids and screening for valuable secondary metabolites in Salvia sp. suspension cultures. Natural Product Communications 9, 17-20
Marchev, A., Haas, C., Schulz, S., Georgiev, V., Steingroewer, J., Bley, Th., Pavlov, A. (2014) Biotechnology of Sage: a promising tool for production of bioactive terpenes and phenolic substances. Biotechnology Letters, 36: 211-221
Wagner K, Friedrich S, Bley T, Schilling N, Boschke E (2013) Modular microfluidic system for the investigation of adhesion and microbial biofilm formation on non-transparent surfaces. Eng Life Sci., DOI: 10.1002/elsc.201200035
Urit T, Manthey R, Bley T, Löser C (2013) Formation of ethyl acetate by Kluyveromyces marxianus on whey: influence of aeration and inhibition of yeast growth by ethyl acetate. Eng. Life Sci. 13(3) 247-260
Moeller L, Zehnsdorf A, Aurich A, Barth G, Bley T, Strehlitz B (2013) Citric acid production from sucrose by recombinant Yarrowia lipolytica using semicontinuous fermentation. Eng. Life Sci. 13(2) 163-171
Moeller L, Zehnsdorf A, Aurich A, Bley T, Strehlitz B (2012) Substrate utilization by recombinant Yarrowia lipolytica growing on sucrose. Applied Microbiology and Biotechnology 93, 1695-1702
Kottmeier K, Günther T, Weber J, Kurtz S, Ostermann K, Rödel G, Bley T (2012) Surface active hydrophobin HFB1 from Trichoderma reesei expressed in Pichia pastoris pre-purified using foam separation during cultivation. Eng. Life Sci. 12, 162-170
Urit T, Löser C, Stukert A, Bley T (2012) Formation of ethyl acetate by Kluyveromyces marxianus on whey during aerobic batch cultivation at specific trace-element limitation. Applied Microbiology and Biotechnology 96, 1313-1323
Lenk F, Vogel M, Bley T, Steingroewer J (2012) Determining Morphological Development and Secondary Metabolite Accumulation in Hairy Root Networks. Eng. Life Sci., 12(6), 588-594
Mauermann M, Bellmann C, Calvimontes A, Caspari A, Bley T, Majschak JP (2012) Reinigbarkeit von Oberflächen in der Lebensmittelindustrie durch Flüssigkeitsstrahlen. Chemie Ingenieur Technik 84, 1568-1574
Löser C, Urit T, Förster S, Stukert A, Bley T (2012) Formation of ethyl acetate by Kluyveromyces marxianus on whey during aerobic batch and chemostat cultivation at iron limitation Applied Microbiology and Biotechnology 96, 685-696
Günther S, Koch C, Hübschmann T, Röske I, Müller R, Bley T, Harms H, Müller S (2012) Correlation of community dynamics and process parameters as a tool for the prediction of the stability of wastewater treatment Environmental Science & Technology 46, 84-92
Boschke E, Henseleit A, Schmieder S, Bley T, Sonntag F, Schilling N, Quenzel P, Danz N, Klotzbach U (2011) A compact and rapid aptasensor platform based on surface plasmon resonance. Eng. Life Sci. 11, 573-579
Georgiev V, Marchev A, Haas C, Weber J, Nikolova M, Pavlov A (2011) Production of oleanolic and ursolic acids by callus culture of Salvia tomentosa Mill. Biotechnology and Biotechnological Equipment 25, 4 Suppl. 34-38
Boehmer U, Frömmel S, Bley T, Müller M, Frankenfeld K, Miethe P (2011) Solid-state fermentation of lignocellulotic materials for the production of enzymes by the white-rot fungus, Trametes hirsuta, in a modular bioreactor. Eng. Life Sci. 11, 395-401
Trutnau M, Petzold M, Mehlig L, Eschenhagen M, Geipel K, Müller S, Bley T, Röske I (2011) Using a carbon based ASM3 EAWAG Bio-P for modelling the enhanced biological phosphorus removal (EBPR) in anaerobic/aerobic activated sludge systems. Bioproc. Biosyst. Engin. 34, 287-295
Stancheva N, Weber J, Schulze J, Alipieva K, Ludwig-Müller J, Haas C, Georgiev V, Bley T, Georgiev M (2011) Phytochemical and flow cytometric analyses of Devil´s claw cell cultures Plant Cell Tissue and Organ Culture 105, 79-84
Walther T, Reinsch H, Ostermann K, Deutsch A, Bley T (2011) Applying Dimorphic Yeasts as Model Organisms to Study Mycelial Growth: Part 2: Application of Mathematical Models to Identify Different Construction Principles in Yeast Colonies. Bioprocess and Biosystems Engineering, 34, 21-31
Walther T, Reinsch H, Weber P, Ostermann K, Deutsch A, Bley T (2011) Applying Dimorphic Yeasts as Model Organisms to Study Mycelial Growth: Part 1: Experimental Investigation of the Spatio-temporal Development of Filamentous Yeast Colonies. Bioprocess and Biosystems Engineering, 34, 13-20
Ed.: Müller S and Bley T (2011) High Resolution Microbial Single Cell Analytics. Series: Advances in Biochemical Engineering/Biotechnology, Vol. 124, Springer-Verlag Berlin Heidelberg, ISBN-Print: 978-3-642-16886-4
Kottmeier K, Ostermann K, Bley T, Rödel G (2011) Hydrophobin signal sequence mediates efficient secretion of recombinant Proteins in Pichia pastoris. Applied Microbiology and Biotechnology 91, 133-141
Löser C, Urit T, Nehl F, Bley T (2011) Screening of Kluyveromyces strains for the production of ethyl acetate: Design and evaluation of a cultivation system. Engineering in Life Sciences, DOI: 10.1002/elsc.201000178
Moeller L, Grünberg M, Zehnsdorf A, Aurich A, Bley T, Strehlitz B (2011) Repeated Fed-Batch Fermentation Using Biosensor online Control for Citric Acid Production by Yarrowia lipolytica. Journal of Biotechnology 153, 133–137
Gyurkovska V, Alipieva K, Maciuk A, Dimitrova P, Ivanovska N, Haas C, Bley T, Georgiev M (2011) Anti-inflammatory activity of Devil’s claw in vitro systems and their active constituents. Food Chemistry 125, 171-178
Muffler K, Leipold D, Scheller MC, Haas C, Steingroewer J, Bley T, Neuhaus HE, Mirata MA, Schrader J, Ulber R (2011) Biotransformation of triterpenes. Process Biochemistry 40, 1-15
Urit T, Löser C, Wunderlich M, Bley T (2011) Formation of ethyl acetate by Kluyveromyces marxianus on whey: studies of the ester stripping. Bioproc. Biosyst. Engin. 34, 547–559
Georgiev M, Ludwig-Müller J, Weber J, Stancheva N, Bley T (2011) Bioactive Metabolite Production and Stress-related Hormones in Devil’s Claw Cell Suspension Cultures Grown in Bioreactors. Applied Microbiology and Biotechnology 89, 1683-1691
Bley T (2011) From single cells to microbial population dynamics: Modelling in biotechnology based on measurements of individual cells. Advances in Biochemical Engineering Biotechnology 124, 211-227
Weber J, Georgiev V, Haas C, Bley T, Pavlov A (2010) Ploidy levels in Beta vulgaris (red beet) plant organs and in vitro systems. Engineering in Life Sciences, 10, 139-147
Böhmer U, Kirsten C, Bley T, Noack M (2010) Use of lignite granules and lignitic xylite combined with white rot fungi as a novel method to treat wastewater from the textile industry. Engineering in Life Sciences, 10, 26-34
Trutnau M, Bley T, Ondruschka J (2010) Chitosan from fungi, In: Chitosan: Manufacture, Properties, and Usage, Ed. Davis SP, Nova Science Publishers, New York
Moeller L, Grünberg M, Zehnsdorf A, Strehlitz B, Bley T (2010) Biosensor Online Control of Citric Acid Production from Glucose by Yarrowia lipolytica Using Semicontinuous Fermentation. Engineering in Life Sciences, 10, 311-320. DOI: 10.1002/elsc.200900073
Weber J, Georgiev V, Haas C, Bley T, Pavlov A (2010) Ploidy levels in Beta vulgaris (red beet) plant organs and in vitro systems. Engineering in Life Sciences 10(1), 1–9
Böhmer U, Kirsten C, Bley T, Noack M (2010) White-rot fungi combined with lignite granules and lignitic xylite to decolorize textile industry wastewater. Engineering in Life Sciences 10(1), 26–34
Pavlov A, Berkov S, Weber J, Bley T (2009) Hyoscyamine biosynthesis in Datura stramonium Hairy root in vitro systems with different ploidy levels. Appl. Biochem. Biotechnol., 157, 210-225
Trutnau M, Suckale N, Groeger G, Bley T, Ondruschka J (2009) Enhanced chitosan production and modeling hyphal growth of Mucor rouxii interpreting the dependence of chitosan yields on processing and cultivation time. Engineering in Life Sciences 9, 437-443
Bley, T. (Hrsg.) Biotechnologische Energieumwandlung - Gegenwärtige Situation, Chancen und künftiger Forschungsbedarf. acatech DISKUTIERT, Springer-Verlag Berlin, Heidelberg 2009
Stottmeister U, Bley Th (2009) Forschung zur Technikbewertung und -gestaltung in der Denkströme, Journal der Sächsischen Akademie der Wissenschaften, Leipziger Universitätsverlag ISSN 1867-6413, 219-226
Georgiev V, Weber J, Bley T, Pavlov A (2009) Improved procedure for nucleus extraction for DNA measurements by flow cytometry of red beet (Beta vulgaris L.) hairy roots. Journal of Bioscience and Bioengineering (107), 439-441
Günther S, Trutnau M, Kleinsteuber S, Bley T, Röske I, Harms H, Müller S (2009) Dynamics of polyphosphate accumulating bacteria in waste water treatment plant communities detected via DAPI (4´,6´-Diamidino-2-Phenylindole) and tetracycline labeling. Appl. Environ. Microbiol. (75), 2111-2121
Mauermann M, Eschenhagen U, Bley T, Majschak JP (2009) Surface Modifications – Application Potential for the Reduction of Cleaning Costs in the Food processing Industry. Trends in Food Science and Technology 20, 8-15
Hortsch R, Löser C, Bley T (2008) A two-stage CSTR cascade for studying the effect of inhibitory and toxic substances in bioprocesses. Engineering in Life Sciences (6), 650-657
Georgiev V, Stukert A, Bley T, Pavlov A (2008) Hyosciamine biosynthesis by diploid and tetraploid Datura stramonium L. hairy root cultures in a temporary immersion cultivation system. Advances in Bulgarian Sciences (2-3), 42-47
Mauermann M, Majschak JP, Eschenhagen U, Bley Th (2008) Reduzierung der Reinigungskosten: Modifizierte Oberflächen verringern Verschmutzungen. Journal für Oberflächentechnik (48), 70-74
Weber J, Georgiev V, Pavlov A, Bley T (2008) Flow cytometric investigations of diploid and tetraploid plants and in vitro cultures of Datura stramonium and Hyoscyamus niger. Cytometry A (73A), 931-93
Haas C, Weber J, Müller-Ludwig J, Deponte S, Bley T, Georgiev MI (2008) Flow cytometry and phytochemical analysis of a sunflower cell suspension culture in a 5-L bioreactor. Zeitschrift für Naturforschung (63), 699-705
Georgiev MI, Georgiev V, Weber J, Bley T, Ilieva M, Pavlov AI (2008) Agrobacterium rhizogenes-mediated genetic transformations: Powerful tool for metabolites production. In: Genetically Modified Plants, Ed. T. V. Wolf & J. P. Koch, Nova Science Publishers
Ondruschka J, Trutnau M, Bley T (2008) Gewinnung und Potentiale des Biopolymers Chitosan. Chemie Ingenieur Technik, Chemie Ingenieur Technik 80(6), 811-818
Georgiev V, Pavlov A, Ilieva M, Bley T (2008) Betalains production in plant in vitro systems. Acta Physiologiae Plantarum, DOI 10.1007/s11738-008-0170-6
Bertau M, Katzberg M, Bley T (2008) Mit einer Tasse Kaffee zu neuen Wirkstoffen Chirale pharmazeutische Intermediate in höherer Stereoisomerenreinheit. BioForum 1, 49-51
Müller S, Bley T (2008) Flow Cytometry for Bioprocess Monitoring - Applications for Procaryotes and cell Cultures. Wiley Encyclopedia of Industrial Biotechnology
Eschenhagen U, Eschenhagen M, Ludwig F, Kiessling A, Symank K, Boschke E, Röske I, Bley T (2008) In situ hybridization of microcolonies using catalyzed reporter deposition with Tetramethylbenzidine – a method for detecting low numbers of bacterial cells in drinking water. European Food Research and Technology
Noack S, Klöden W, Bley T (2007) Modeling synchronous growth of bacterial populations in phased cultivation. Bioprocess and Biosystems Engineering, DOI: 10.1007/s00449-007-0180-6
Moeller L, Strehlitz B, Aurich A, Zehnsdorf A, Bley, Th (2007) Optimization of citric acid production from glucose by Yarrowia lipolytica. Engineering in Life Sciences 7, 504-511
Bohn M, Leppchen K, Katzberg M, Steingroewer J, Weber J, Bley T, Bertau M (2007) Effects of caffeine on stereoselectivities of high cell density biotransformations of cyclic ß-keto esters with Saccharomyces cerevisiae. Organic & Biomolecular Chemistry 5, 3456-3463
Pavlov AI, Georgiev MI, Bley T (2007) Batch and Fed-batch production of betalains by red beet (Beta vulgaris) hairy roots in a bubble column reactor. Zeitschrift für Naturforschung 62c, 439-446
Georgiev MI, Pavlov AI, Bley T (2007) Hairy root type plant in vitro systems as source of bioactive substances. Applied Microbiology and Biotechnology 74, 1175-1185
Steingroewer J, Bley T, Bergemann C, Boschke E (2007) Biomegnetc separation of Salmonella typhimurium with high affine and specific ligand peptides isolated by Phage Display Technique. Journal of Magnetism and Magnetic Materials 311, 295-299
Starruß J, Bley T, Sogaar-Andersen L, Deutsch A (2007) A new mechanism for collective migration in Myxococcus xanthus. Journal of Statistical Physics 128, 269-286
Boschke E, Böhmer U, Lange J, Constapel M, Schellenträger M, Bley T (2007) The use of respirometric measurements to determine the toxicity of textile dyes in aqueous solution and after oxidative decolourisation processes. Chemosphere 67, 2163-2168
Zosel J, Enseleit U, Opitz T, Bley T, Guth U (2006) Einsatz hochempfindlicher Gassensoren für das Monitoring der Aktivität von Schimmelpilzkulturen. Der Versuchs- und Forschungsingenieur 39, 31-37
Bernhardt G, Bley T (2006) Kompetenzzentrum integrierte Naturstofftechnik - ZINT. Landtechnik 61, 65
Ondruschka J, Groeger G, Geyer W, Bley T (2006) Fermentative Herstellung von Chitosan aus Pilzmyzelien. Chemie Ingenieur Technik 78, 479-483
Pavlov A, Bley T (2006) Betalains biosynthesis by Beta vulgaris L. hairy root culture in a temporary immersion system. Process Biochemistry 41, 848-852
Pich A, Bhattacharya S, Adler H-JP, Wage T, Taubeberger A, Li Z, van Pee K-H, Böhmer U, Bley T (2006) Composite magnetic particles as carriers for laccase from Trametes versicolor. Macromolecular Biosciences 6, 301-310
Bernhardt G, Bley T (2006) Kompetenzzentrum integrierte Naturstofftechnik - ZINT. Landtechnik 61, 65
Weber J, Bühner J, Bley T, Göhde R (2006) Populationen überwachen - Durchflußzytometrisches Online-Monitoring zur Prozesssteuerung. BioTec (5-6), 32-33
Böhmer U, Suhardi SH, Bley T (2006) Decolorizing reactive textile dyes by white – rot fungi using temporary lift up immersion cultivation Eng. Life Sci. 6, 417-420
Georgiev M, Heinrich M, Kerns G, Bley T, Pavlov A (2006) Production of iridoids and phenolics by transformed Harpagophytum procumbens root cultures. Eng. Life Sci. 6, 593-596
Groeger G, Geyer W, Bley T, Ondruschka J (2006) Fermentative Herstellung von Chitosan aus Pilzmycelien. Chemie Ingenieur Technik 78 (4), 479-483
Onyango C, Bley T, Jacob A, Henle T, Rohm H (2006) Influence of incubation temperature and time on resistant starch type III formation from autoclaved and acid-hydrolysed cassava starch. Carbohydrate Polymers 66, 494-499
Steingroewer J, Bley T, Boschke E (2006) Schnellnachweis von Mikroorganismen, Biomagnetische Separation in einem neuen Testverfahren. LVT Lebensmittel-Industrie 51(1), 54-56
Fritsch M, Starruß J, Loesche A, Mueller S, Bley T (2005) Cell Cycle Synchronization of Ralstonia eutropha by Continuous Phasing Measured via Flow Cytometry. Biotechnol. Bioeng. 92, 635-642
Walther T, Reinsch H, Ostermann K, Deutsch A, Bley T (2005) Coordinated development of yeast colonies. A) Experimental analysis of the adaptation to different nutrient concentrations. Eng. Life Sci. 5, 115-124
Walther T, Reinsch H, Ostermann K, Deutsch A, Bley T (2005) Coordinated development of yeast colonies. B) Quantitative modeling of diffusion-limited growth. Eng. Life Sci. 5, 125-133
Pavlov A, Werner S, Ilieva M, Bley T (2005) Characteristic of Helianthus annus plant cell culture as a producer of immunologically active exopopolysaccharides. Eng. Life Sci. 5, 280-283
Löser C, Schröder A, Deponte S, Bley T (2005) Balancing the ethanol formation in continuous bioreactors with ethanol stripping. Eng. Life Sci. 5, 325-332
Pavlov A, Kovatcheva P, Tuneva D, Ilieva M, Bley T (2005) Radical Scavenging Activity and Stability of Betalains from Beta vulgaris hairy root culture in Simulated Conditions of Human Gastrointestinal Tract. Plant Foods for Human Nutrition 60, 43-47
Boschke E, Steingroewer J, Bley T (2005) Einsatz der Biomagnetischen Separation zur mikrobiologischen Qualitätskontrolle von Lebensmitteln. Chemie Ingenieur Technik 77(7), 912-919
Onyango C, Noetzold H, Ziems A, Hofmann T, Bley T, Henle T (2005) Digestibility and antinutrient properties of acidified and extruded maize-finger millet blend in the production of Uji. Food Science and Technology 38, 697-707
Steingroewer J, Knaus H, Bley T, Boschke E (2005) Rapid Method for Pre-Enrichment and Detection of Salmonella typhimurium. Eng. Life Sci. 5, 267-272
Steingroewer J, Boschke E, Bley T (2004) Biomagnetische Separation zur mikrobiologischen Qualitätskontrolle von Lebensmitteln. 12. Heiligenstätter Kolloquium:"Technische Systeme für Biotechnologie und Umwelt", Tagungsband, 225-236
Deponte S, Steingroewer J, Löser C, Boschke E, Bley T (2004) Biomagnetic separation of Escherichia coli by use of anion-exchange beads: measurement and modeling of the kinetics of cell-bead interactions. Analytical and Bioanalytical Chemistry 379 (3), 419-26
Achilles J, Müller S, Bley T, Babel W (2004) Affinity of single S.cerevisiae cells to 2-NDBglucose under changing substrate conditions. Cytometry 61A, 88-98
Fialova A, Boschke E, Bley T (2004) Rapid monitoring of the biodegradation of phenol-like compounds by the yeast Candida maltosa using BOD measurements. International Biodeterioration & Biodegradation 54, 69-76
Onyango C, Bley T, Raddatz H, Henle T (2004) Flavour compounds in backslop fermented uji (an East African sour porridge). European Food Research and Technology 218, 579-583 doi 10.1007/s00217-003-0870-5
Onyango C, Henle T, Hofmann T, Bley T (2004) Production of high energy density fermented uji using a commercial alpha-amylase or by single-screw extrusion. LWT - Food Science and Technology 37, 401-407
Onyango C, Henle T, Ziems A, Hofmann T, Bley T (2004) Effect of extrusion variables on fermented maize-finger millet blend in the production of uji. LWT - Food Science and Technology 37, 409-415
Onyango C, Noetzold H, Bley T, Henle T (2004) Proximate composition and digestibility of fermented and extruded uji from maize-finger millet blend. LWT - Food Science and Technology 37, 827-832
Walther T, Reinsch H, Große A, Ostermann K, Deutsch A, Bley T (2004) Mathematical modeling of regulatory mechanisms in yeast colony development. Journal of Theoretical Biology 229, 327-338
Boschke E, Eschenhagen U, Bley T (2003) Schnelle Detektion von Keimen mittels Fluoreszenz in situ Hybridisierung. Swiss Pharma 25 (5), 5-11
Bley T (2003) Bioverfahrenstechnik - Ein neuer Partner in der deutschen Verfahrenstechnik. Wissenschaftliche Zeitschrift der TU-Dresden 52:4, 53-57
Ondruschka J, Bley T (2003) Biosorption of environmetally relevant heavy metals on slected biomaterials for wastewater treatment. Engineering in Life Sciences 3, 215-218
Boschke E, Steingroewer J, Ripperger S, Klingner E, Bley T (2002) Biomonitoring by combination of immunomagnetic separation and direct epifluorescence filter technique. European Cells and Materials 3 (Suppl.2), 146-147
Walther T, Ostermann K, Listewnik H-F, Rödel G, Bley T (2002) Verfahren zur biotechnologischen Herstellung von Xylit. Patent-Nr: DE 10222373.4-42
Bley T, Müller S (2002) How should microbial life be quantified to optimise bioprocesses. Acta Biotechnologica 22, 401-409
Boschke E, Eschenhagen U, Bühner J, Bley T (2002) Lebensmittelverderbern und Kontaminanten auf der Spur. BIOforum 6, 472-475
Ondruschka J, Bley T (2002) Biosorption umweltrelevanter Schwermetalle an ausgewählten Biomaterialien als Grundlage für die Reinigung belasteter Abwässer. Chemie Ingenieur Technik 74, 500-504
Boschke E, Schünemann K, Bley T (2000) Enzymatische Probenaufbereitung für die nachfolgende Detektion von Mikroorganismen in ausgewählten Stoffsystemen aus dem Bereich der Lebensmittelindustrie. Lebensmittel- und Verpackungstechnik 45, 299-301
Hardjito L, Bley T (2000) A model for biopigment formation by Serratia marcescens biovar A2/6 in batch culture containing lactic acid and beef extract. Acta Biotechnologica 20, 75-81
Simon D, Müller R H, Große H J, Bley T, Babel W (2000) Response of Ralstonia eutropha JMP 134 to long-term exposure to toxic substrates in nutristat cultivation as indicated by on-line fluorescence measurements. Bioprocess Engineering 23, 1-10
Müller S, Bley T (1999) Flow Cytometry. In: The Encyclopedia of Bioprocess Technology: Fermentation, Biocatalysis and Bioseparation, M C Flickinger, S W Drew (Eds), 1226 - 1238, John Wiley, New York
Müller S, Hutter KJ, Bley T (1999) Flow cytometric characterization of physiological states of brewer's yeast in industrial processes In: Food microbiology and food safety into the next millenium. 191-195. Ed.: Tujitelaars et al., Ponsen et Looyen, Wageningen
Müller S, Bley T, Babel W (1999) Adaptive responses of Ralstonia eutropha to feast and famine conditions analysed by flow cytometry. Journal of Biotechnology 75, 81-97
Große-Uhlmann R, Bley T (1999) A modular approach to situation identification of the dynamics of bacterial populations synthesizing poly-ß-hydoxybutyrate. Bioprocess Engineering 21, 191-200
Boschke E, Bley T (1998) Growth patterns of yeast colonies depending on nutrient supply. Acta Biotechnologica 18, 17-27
Werner A, Boschke E, Bley T (1997) Immobilisierung fettspaltender Mikroorganismen zur Reinigung fetthaltiger Abwässer der Lebensmittelindustrie. Wissenschaftliche Zeitschrift der Technischen Universität Dresden 46, 33-39
Müller S, Hutter K J, Bley T, Petzold L, Babel W (1997) Dynamics of yeast cell states during proliferation and non proliferation periods in a brewing reactor monitored by multidimensional flow cytometry. Bioprocess Engineering 17, 287-293
Herrmann C, Lösche A, Müller S, Bley T, Babel W. (1997) Flow cytometric discrimination between Acinetobacter calcoaceticus 69-V and Alcaligenes eutrophus JMP 134 by fluorescently labelled rRNA-targeted oligonucleotide probes and DNA staining. Acta Biotechnolica 17, 19-38
Bley T, Albrecht K F, Miethe D, Riis V, Babel W (1996) Describing microbial degradation processes with the evolon model. Acta Biotechnolica 16, 237-244
Müller S, Loffhagen N, Bley T, Babel W (1996) Membrane-potential-related fluorescence intensity indicates bacterial injury. Microbiolical Research 151, 127-131
Simon D, Müller R H, Bley T, Babel W (1996) Correlation between cellular fluorescence and NAD(P)H levels in Alcaligenes eutrophus JMP 134. Bioprocess Engineering 14, 57-62
Bley T, Müller S, Lösche A, Ackermann J U, Babel W (1995) Flow cytometric monitoring of bacterial cell states under growth limiting conditions. In: Computer Applications in Biotechnology, A Munack, K Schügerl (Eds), Pergamon Press, Oxford, 213-216
Müller R H, Bley T, Babel W (1995) Transient state cultivation as a means for determining maximum growth rates in inhibition kinetics. Journal of Microbiolological Methods 22, 209-219
Miethe D, Albrecht K F, Riis V, Bley T, Babel W (1995) Description of the microbial degradation process for mineral oils and its extrapolation by the evolon model. In: Contaminated Soil ´95, W J van den Brink, R Bosman, F Arendt (Eds), Kluwer Academic Publishers, 1305-1306
Ackermann J U, Müller S, Lösche A, Bley T, Babel W (1995) Methylobacterium rhodesianum cells tend to double the DNA content under growth limitations and accumulate PHB. Journal of Biotechnology 39, 9-20
Müller S, Lösche A, Bley T, Scheper T (1995) A flow cytometric approach for characterization and differentiation of bacteria during microbial processes. Applied Microbiology and Biotechnology 43, 93-101
Lösche A, Müller S, Bley T (1994) Flow Cytometry - Charakterisierung von Bakterien. BIOforum 17, 56-60
Müller S, Lösche A, Bley T (1993) Staining procedures for flow cytometric monitoring of bacterial populations. Acta Biotechnolica 13, 289-297
Müller S, Lösche A, Bley T (1992) Flow cytometric investigation of sterol content and proliferation activity of yeast. Acta Biotechnologioca 12, 365-375
Bley T (1992) Delay-differential equations for modeling synchrony and periodic phenomena in microbial population dynamics. In: Modeling and control of biotechnical processes, M N Karim, G Stephanopoulos (Eds), Pergamon Press, 195-199
Bley T, Babel W (1992) Calculating affinity constants of substrate mixtures in a chemostat. Acta Biotechnologica 12, 13-15
Lösche A, Müller S, Stoll P, Bley T (1992) Durchflußzytometrie - eine physikalische Meßmethode in der Biotechnologie. Experimentelle Technische Physik 39, 97-102
Degelau A, Freitag R, Linz F, Middendorf C, Scheper T, Bley T, Müller S, Stoll P, Reardon K F (1992) Immuno- and flow cytometric analytical methods for biotechnological research and process monitoring. Journal of Biotechnololgy 25, 115-144
Möckel B, Bley T, Böhme B (1990) Model simulation of an efficient periodic control strategy for continuous fermentation processes. Acta Biotechnolica 10, 395-400
Bley T (1990) State structure models - A base for efficient control of fermentation processes. Biotechnology Advances 8, 233-259
Möckel B, Bley T, Böhme B (1989) Cyclic control of continuous biotechnological processes on the basis of a hierarchical control system. Systematic Analysis Modellation and Simulation 6, 181-196
Bley T, Wegner B (1988) Hopf bifurcation for a family of two-state microbial growth models. Acta Biotechnologica 8, 267-275
Möckel B, Böhme B, Bley T (1987) Optimal situation control for biosynthetic processes on the basis of a prediction filter. Acta Biotechnologica 7, 247-256
Bley T, Heinritz B (1987) Modelling and control of yeast growth in biotechnical systems. In: Dynamical Systems and Environmental Models, Akademie-Verlag Berlin, 213-219
Bley T (1987) State-structure models of microbial growth. Acta Biotechnologica 7, 173-177
Heinritz B, Bley T, Ringpfeil M (1985) Einsatz von Hochleistungsreaktoren zur mikrobiologischen Stoffwandlung. Chemie und Technik 37, 514-516
Heinritz B, Bley T (1985) State-models - An appropriate tool for improving the efficiency of biotechnical processes. In: Lotka-Volterra-Approach to Cooperation and Competition in Dynamical Systems, W Ebeling, M Peschel (Eds), Akademie-Verlag Berlin
Bley T, Heinritz B, Schmidt A (1984) Some stationary properties of a two-state microbial growth model for continuous fermentation derived from the Smith and Martin hypothesis. Studia Biophysica 98, 119-124
Bogner H, Bley T, Schneider K R (1984) Time optimal control for a growth model. Systematic Analysis Modellation and Simulation 1, 425-437
Heinritz B, Rogge G, Stichel E, Bley T (1983) Use of biorhytmic processes for increasing the efficiency of carbon-compound conversion by microorganisms. Acta Biotechnologica 3, 125-131
Heinritz B, Stichel E, Bley T, Glombitza F (1982) Theoretische Bestimmung energetischer Wirkungsgrade der mikrobiellen Kohlenstoffsubstratwandlung und Vergleich mit experimentellen Werten an Phasenkulturen. Zeitschrift für Allgemeine Mikrobiologie 22, 535-544
Stichel E, Rogge G, Bley T, Heinritz B (1982) Yield coefficients in dependence on milieu conditions and cell states. III. Induction of synchrony in continuous yeast cell cultivation by milieu changes. Zeitschrift für Allgemeine Mikrobiologie 22, 717-722
Heinritz B, Stichel E, Bley T, Rogge G, Glombitza F (1981) Yield coefficients in dependence on milieu conditions and cell states. II. Influence of pertubations on continuous cultivation of the yeast Lodderomyces elongisporus on hydrocarbons. Zeitschrift für Allgemeine Mikrobiologie 21, 583-588
Kuchenbecker D, Bley T, Schmidt A (1981) Short-periodic oscillations of culture fluorescence in yeast cell populations. stud biophysics 86, 157-162
Bley T, Bogner H (1981) Optimal control of a structured growth model. stud biophysics 83, 217-224
Bley T, Schmidt A (1980) A two state microbial growth model for continuous fermentation. Studia Biophysica 78, 11-12
Bley T, Heinritz B, Steudel A, Stichel E, Glombitza F, Babel W (1980) Yield coefficients in dependence on milieu conditions and cell states. I. Synchronized batch growth of a yeast. Zeitschrift für Allgemeine Mikrobiologie 20, 283-286
Heinritz B, Bley T (1979) Einfluß alternierender Störungen auf die Verbrauchskennziffern beim Wachstum von Mikroorganismen. Zeitschrift für Allgemeine Mikrobiologie 19, 247-252
Loffhagen N, Bley T, Babel W (1979) Regulation of pyruvate carboxylase from "hexulosephosphate pathway bacteria". Zeitschrift für Allgemeine Mikrobiologie 19, 367-372